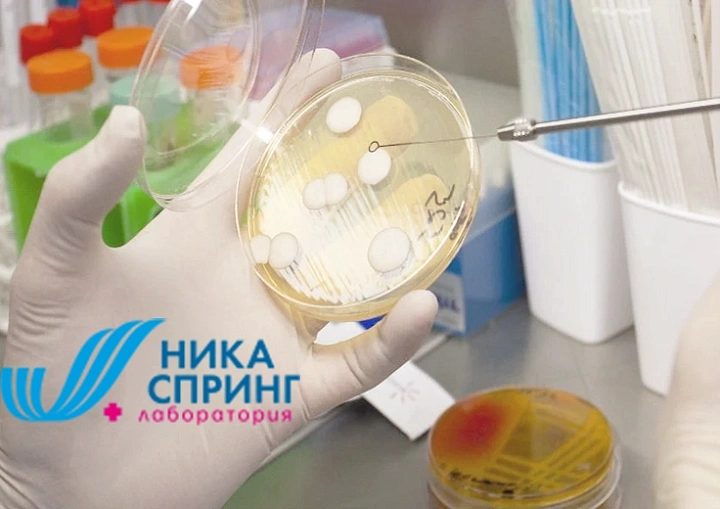
Изображение для категории Бактериология

Вы можете сдать анализ на «Иерсиниоз IgG» в Нижнем Новгороде и Нижегородской области, обратившись в лабораторию клиники «НИКА СПРИНГ». Узнать точные цены на анализы «Иерсиниоз IgG» в ближайшем к Вам филиале клиники можно по телефону +7 (831) 26-00-226.
После посещения клиники можно сформировать справку для налогового вычета на нашем сайте.
*Срок выполнения исследования может меняться, уточняйте у администратора.
**Тариф (стоимость) отдельного исследования, указанный в настоящем прайс-листе, может отличаться от тарифа (стоимости) такого же исследования в отдельном медицинском центре (клинике / лаборатории) «НИКА СПРИНГ» не более, чем на 10% в сторону увеличения.
Со списком исследований, на которые не начисляются и не списываются бонусы по "Программе лояльности НИКА СПРИНГ" можно ознакомиться по ссылке.
Иерсиниоз IgG Иерсиниоз
Кишечный (интестинальный) иерсиниоз
Псевдотуберкулёз
Исследование на антитела IgG
0,8 - 1,1 - сомнительный, рекомендуется повторить через 10-14 дней;
>1,1 - антитела обнаружены
Положительный результат: текущая иерсиниозная инфекция (псевдотуберкулез / кишечный иерсиниоз), ранее перенесенная иерсиниозная инфекция (псевдотуберкулез / кишечный иерсиниоз). Сомнительный результат: ранний период болезни (начало образования антител), недавно перенесенная инфекция и снижение специфических антител. При сомнительном результате анализ необходимо повторить через 7-14 дней. Отрицательный результат: отсутствие инфицирования иерсиниями, ранний период инфицирования (до образования антител) или длительный период после выздоровления.